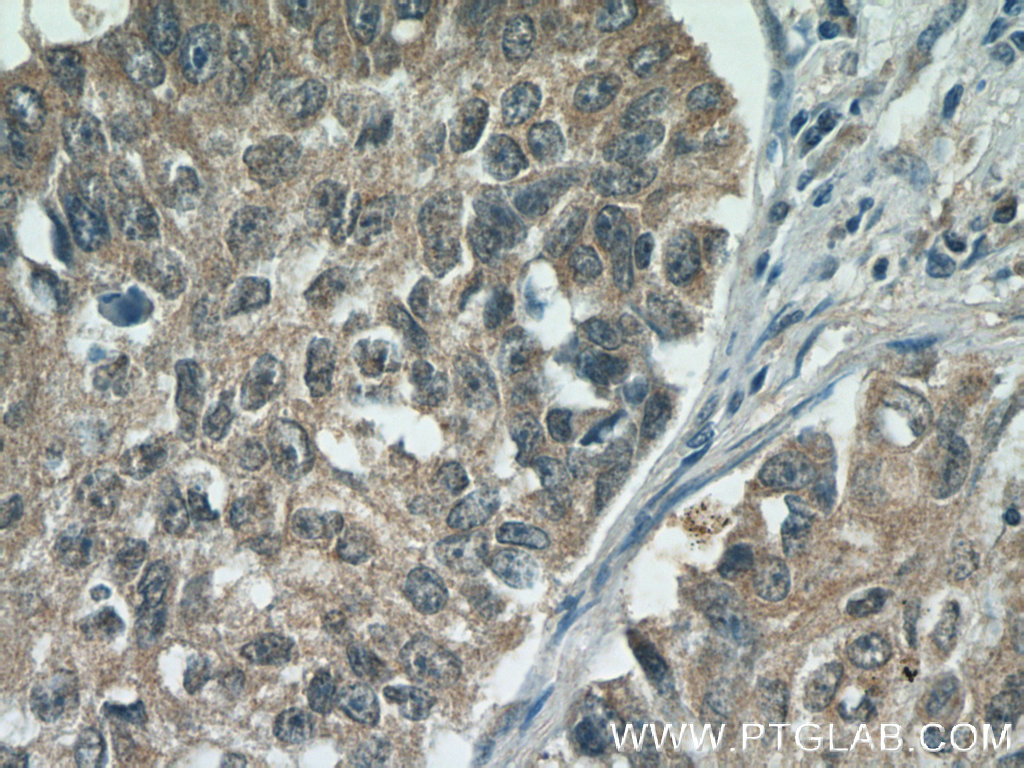

KIAA0907抗体
产品名称: KIAA0907抗体
英文名称: KIAA0907Antibody
产品编号: XY 25419-1
产品价格: null
产品产地: 中国/美国
品牌商标: XYbscience
更新时间: 2023-08-17T09:55:27
使用范围: WB,ELISA,IHC-P,IHC-F,IF
- 联系人 : 徐经理
- 地址 : 上海市闵行莘庄工业区春东路508号A1-2F
- 邮编 : 200612
- 所在区域 : 上海
- 电话 : 152****8802 点击查看
- 传真 : 点击查看
- 邮箱 : shxysw02@163.com
- 二维码 : 点击查看
KIAA0907抗体
XY488Hu22 角蛋白5(KRT5)单克隆抗体 Monoclonal Antibody to Keratin 5 (KRT5) Homo sapiens (Hukl)
XY489Hu22 角蛋白4(KRT4)单克隆抗体 Monoclonal Antibody to Keratin 4 (KRT4) Homo sapiens (Hukl)
XY491Hu22 角蛋白2(KRT2)单克隆抗体 Monoclonal Antibody to Keratin 2 (KRT2) Homo sapiens (Hukl)
XY492Hu22 角蛋白1(KRT1)单克隆抗体 Monoclonal Antibody to Keratin 1 (KRT1) Homo sapiens (Hukl)
XY500Hu22 嵌套蛋白(NES)单克隆抗体 Monoclonal Antibody to Nestin (NES) Homo sapiens (Hukl)
XY512Hu22 纤维介素蛋白(FGL2)单克隆抗体 Monoclonal Antibody to Fibrinogen Like Protein 2 (FGL2) Homo sapiens (Hukl)
XY514Hu22 失调蛋白1(ATXN1)单克隆抗体 Monoclonal Antibody to Ataxin 1 (ATXN1) Homo sapiens (Hukl)
XY516Hu22 角蛋白16(KRT16)单克隆抗体 Monoclonal Antibody to Keratin 16 (KRT16) Homo sapiens (Hukl)
XY519Hu22 载脂蛋白A1(APOA1)单克隆抗体 Monoclonal Antibody to Apolipoprotein A1 (APOA1) Homo sapiens (Hukl)
XY520Hu22 蛋白激酶R(PKR)单克隆抗体 Monoclonal Antibody to Protein Kinase R (PKR) Homo sapiens (Hukl)
XY522Hu22 角蛋白14(KRT14)单克隆抗体 Monoclonal Antibody to Keratin 14 (KRT14) Homo sapiens (Hukl)
XY525Hu22 组织型纤溶酶原激活因子(tPA)单克隆抗体 Monoclonal Antibody to Plasminogen Activator, Tissue (tPA) Homo sapiens (Hukl)
XY528Hu22 血小板衍生生长因子A(PDGFA)单克隆抗体 Monoclonal Antibody to Platelet Derived Growth Factor Subunit A (PDGFA) Homo sapiens (Hukl)
XY529Hu22 血栓调节蛋白(TM)单克隆抗体 Monoclonal Antibody to Thrombomodulin (TM) Homo sapiens (Hukl)
XY531Hu22 纤溶酶原激活物抑制因子2(PAI2)单克隆抗体 Monoclonal Antibody to Plasminogen Activator Inhibitor 2 (PAI2) Homo sapiens (Hukl)
XY532Hu22 纤溶酶原激活物抑制因子1(PAI1)单克隆抗体 Monoclonal Antibody to Plasminogen Activator Inhibitor 1 (PAI1) Homo sapiens (Hukl)
XY533Hu22 细胞间粘附分子3(ICAM3)单克隆抗体 Monoclonal Antibody to Intercellular Adhesion Molecule 3 (ICAM3) Homo sapiens (Hukl)
XY534Hu22 细胞间粘附分子2(ICAM2)单克隆抗体 Monoclonal Antibody to Intercellular Adhesion Molecule 2 (ICAM2) Homo sapiens (Hukl)
XY536Hu22 亮氨酰氨基肽酶(LAP)单克隆抗体 Monoclonal Antibody to Leucine Aminopeptidase (LAP) Homo sapiens (Hukl)
XY539Hu22 髓鞘碱性蛋白(MBP)单克隆抗体 Monoclonal Antibody to Myelin Basic Protein (MBP) Homo sapiens (Hukl)